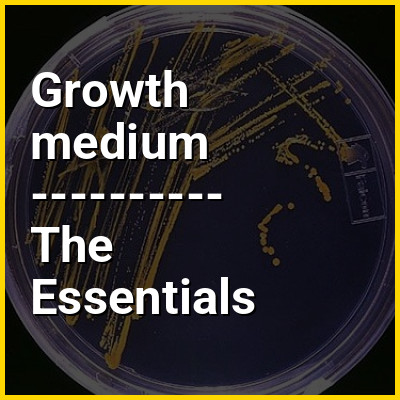

A growth medium or culture medium is a solid, liquid, or semi-solid designed to support the growth of a population of microorganisms or cells via the process of cell proliferation or small plants like the moss Physcomitrella patens. Different types of media are used for growing different types of cells.
The two major types of growth media are those used for cell culture, which use specific cell types derived from plants or animals, and those used for microbiological culture, which are used for growing microorganisms such as bacteria or fungi. The most common growth media for microorganisms are nutrient broths and agar plates; specialized media are sometimes required for microorganism and cell culture growth. Some organisms, termed fastidious organisms, require specialized environments due to complex nutritional requirements. Viruses, for example, are obligate intracellular parasites and require a growth medium containing living cells.